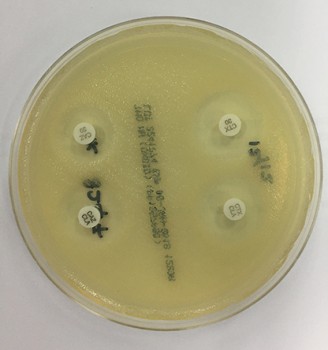
Wereldwijd neemt de prevalentie van extended-spectrumbètalactamaseproducerende bacterieën toe.

Samenvatting
Wereldwijd raken steeds meer mensen geïnfecteerd door extended-spectrumbètalactamase (ESBL) producerende bacteriën. Zagen we ESBL-infecties aanvankelijk vooral in ziekenhuizen, nu krijgen ook huisartsen ermee te maken. Dit komt door de veranderde samenstelling van de (patiënten)populatie en doordat ziekenhuiszorg zich verplaatst naar de huisarts. Bij een infectie door een ESBL-producerende bacterie (EPB) kan de standaardbehandeling niet aanslaat. Huisartsen moeten hierop bedacht zijn als een standaardbehandeling bij infecties faalt en risicofactoren voor dragerschap van EPB aanwezig zijn. Samenwerking tussen de eerste en tweede lijn is essentieel voor de aanpak van dit groeiende probleem.
Resistentie in de huisartsenpraktijk
Antibioticaresistentie is wereldwijd een van de grootste problemen voor de volksgezondheid. In 2050 zullen meer mensen overlijden aan infecties door multiresistente bacteriën, dan aan hart- en vaatziekten of kanker.1 In deze beschouwing bespreken we het probleem van de extended-spectrumbètalactamase (ESBL) producerende bacteriën, en de gevolgen voor de behandeling en preventieve maatregelen. Infecties door deze bacteriën zijn niet alleen een probleem in zorginstellingen, maar komen ook voor in de huisartsenpraktijk.2 ESBL-producerende bacteriën (EPB) zijn resistent tegen bètalactamantibiotica, zoals penicillines, ook in combinatie met een bètalactamaseremmer, zoals co-amoxyclav en cefalosporines, en vaak ook tegen andere klassen van antibiotica.3 Infecties door EPB geven een grotere kans op therapiefalen, en een toename van de morbiditeit en soms mortaliteit.4
ESBL worden (uitsluitend) geproduceerd door Enterobacteriaceae, zoals Escherichia coli, Klebsiella pneumoniae, Enterobactercloacae en Proteus mirabilis. Vooral E. coli en K. pneumoniae produceren vaak een ESBL. Als huisarts moet u bij de behandeling van een urineweginfectie (UWI) en aanwezige risicofactoren op ESBL rekening houden met een EPB: 80% van de EPB wordt gekweekt uit de urine en 80% hiervan betreft een E. coli.5
Nethmap publiceert jaarlijks gegevens over antibioticagebruik en -resistentie van verwekkers, geïsoleerd bij patiënten in de huisartsenpraktijk.6 De meeste isolaten zijn afkomstig uit urines die ingestuurd zijn vanwege therapiefalen.2
Voor de Enterobacteriaceae waren de meeste resistentiepercentages lager dan 30% [tabel]. De percentages hoog resistente micro-organismen (HRMO) en multidrugsresistentie (resistentie tegen zowel cotrimoxazol en fluoroquinolonen) lagen de laatste vijf jaar onder de 5%.2
Het percentage infecties veroorzaakt door EPB was 2,8% in 2015 en 3,1% in 2016. Er was een duidelijke relatie tussen de complexiteit van zorg en het percentage EPB-infecties.2
Bij verwekkers van een UWI zonder tekenen van weefselinvasie is de resistentie voor de door de NHG aanbevolen antibiotica (AB) laag, uitgezonderd trimethoprim met 10 tot 35% resistentie. Bij UWI met tekenen van weefselinvasie, in het bijzonder bij kinderen en zwangeren, lopen de resistentiepercentages op tot boven de 20% [tabel].
| E. coli | K. pneumoniae | P. mirabilis | ||||
|---|---|---|---|---|---|---|
| Leeftijd (jaar) | ≤ 12 | > 12 | ≤ 12 | > 12 | ≤ 12 | > 12 |
| Mediane leeftijd | 5 | 66 | 4 | 73 | 3 | 75 |
| Antibiotica (% resistent) | ||||||
| amoxicilline/ampicilline | 35 | 39 | - | - | 20 | 21 |
| co-amoxiclav | 17 | 20 | 11 | 10 | 6 | 5 |
| ciprofloxacine | 3 | 9 | 0 | 4 | 2 | 7 |
| norfloxacine | 6 | 15 | 6 | 23 | 5 | 12 |
| fosfomycine | 1 | 1 | 22 | 32 | 9 | 17 |
| trimethoprim | 21 | 25 | 10 | 22 | 27 | 35 |
| co-trimoxazole | 20 | 23 | 8 | 11 | 22 | 28 |
| nitrofurantoïne | 0 | 2 | - | - | - | - |
| Multidrugsresistentie HRMO* | 2 | 5 | 1 | 5 | 1 | 2 |
| Multidrugsresistentie† | 1 | 3 | 0 | 2 | 0 | 0 |
Als u een kweek aanvraagt wilt u informatie over de verwekker en de AB-resistentie. U hoeft ‘aanvraag op ESBL’ niet specifiek te vermelden, ook een niet-ESBL is relevant voor het beleid. Het is aan te raden hierover vooraf te overleggen met het samenwerkend laboratorium.
Dragerschap en infectie met epb
Aanwezigheid van een EPB zonder klachten (dragerschap) geeft meestal geen problemen, maar vergroot de kans dat EPB in de toekomst een infectie veroorzaakt.7 Als een gangbaar antibioticum niet werkt en risicofactoren op EPB-dragerschap/-infectie aanwezig zijn, moet u alert zijn op een EPB-infectie. Risicofactoren op een EPB zijn onder andere: afkomstig zijn uit een regio met een hoge antibioticaconsumptie en/of gereisd in landen met een hoge EPB-prevalentie.89 De duur van dragerschap van EPB bij deze laatste groep varieert van drie maanden (bij het merendeel) tot meer dan een jaar bij ruim 11%.10
In 2050 overlijden meer mensen aan infecties door multiresistente bacteriën, dan aan HVZ of kanker
Risico op epb-dragerschap en preventie
Risicofactoren voor EPB-dragerschap zijn gebruik van protonpompremmers, antibioticagebruik en opname in zorginstellingen.1112
Om de kans op verspreiding van EPB te minimaliseren is het zowel in zorginstellingen als in de huisartsenpraktijk belangrijk om infectiepreventieve maatregelen na te leven.12 Verspreiding van EPB’s vindt plaats via contact, urine en ontlasting. Voor uw praktijk gelden de algemene hygiëne- en voorzorgmaatregelen, zoals vermeld in de NHG-Richtlijn Infectiepreventie en aanbevelingen bij bijzonder resistente micro-organismen (BRMO).13 Extra maatregelen zijn niet nodig, ook niet bij zwangeren. Er is geen risico voor de ongeboren vrucht bekend. Ook gezonde huisgenoten van een ESBL-positieve patiënt hoeven geen extra maatregelen te nemen.14 Vaak verdwijnt het dragerschap spontaan. Thuiszorgmedewerkers nemen wel extra maatregelen bij de verzorging van een patiënt met een EPB, zoals het dragen van beschermende kleding.15 Bij dragerschap van een patiënt met een EPB gelden de WIP-richtlijnen.16
Om het risico op verspreiding binnen en tussen zorginstellingen te verkleinen is goede overdracht van alle relevante klinische gegevens noodzakelijk, inclusief antibioticagebruik en uitslagen van microbiologisch onderzoek.17 Een EPB moet u ook (tijdelijk) in het patiëntendossier vermelden.
Bij een bekende EPB-infectie of dragerschap in het verleden (< 12 maanden) is het aan te bevelen voorafgaand aan een antibioticumbehandeling een kweek af te nemen. Dit hoeft niet bij gezonde patiënten zonder klachten. Als een patiënt weet dat hij drager is van een EPB zou hij dit bij de start van een antibioticumbehandeling moeten melden aan de behandelaar. Goede patiëntenvoorlichting is daarom belangrijk.
De vorming van regionale zorgnetwerken (antibioticaresistentie), een regionaal samenwerkingsverband tussen GGD, ziekenhuizen en verpleeghuizen, zal naar verwachting bijdragen aan het optimaliseren van de overdracht tussen zorginstellingen.12 Ook huisartsen moeten geïnformeerd worden over de functie van het netwerk. Hun rol in deze netwerken moet nog uitgewerkt worden. Een van de aandachtspunten van de zorgnetwerken is het optimaliseren van het antibioticabeleid in de eerste en tweede lijn. Zo wordt mogelijk het AB-voorschrijfgedrag van huisartsen een essentieel onderdeel voor de NHG-praktijkaccreditatie.18
In ziekenhuizen zijn voor het optimaliseren van het antibioticabeleid A-teams ingesteld. Een A-team bestaat uit tenminste een internist-infectioloog, een arts-microbioloog en een ziekenhuisapotheker, bij voorkeur aangevuld met een kwaliteitsfunctionaris. Dit team is verantwoordelijk voor het opstellen en implementeren van een antimicrobieel stewardship-programma voor optimale antimicrobiële therapie. Het doel is verbetering van de kwaliteit van de patiëntenzorg, beheersing van de antibioticaresistentie en reductie van de zorgkosten.2 Ook u zult binnenkort met dergelijke A-teams te maken krijgen. Antibioticaresistentie blijft namelijk niet beperkt tot een patiënt of een instelling alleen. Omdat de overheid ziekenhuisverplaatste zorg stimuleert zult u in de toekomst meer te maken krijgen met in een zorginstelling verworven infecties en antibioticaresistenties.
Voeding en milieu
Naast mogelijke overdracht van EPB van mens tot mens kan verspreiding ook via voeding en milieu plaatsvinden. Rauw vlees (in het bijzonder kip en kalkoen) en groenten die vooral ongekookt gegeten worden zijn potentiële bronnen van EPB voor de mens. Het is niet bekend welke risico’s deze producten hebben voor verspreiding van EPB naar de mens en welke bijdrage ze leveren aan het resistentieprobleem bij de mens. 19 22
Reizigers
Door een toename van de globalisering en geavanceerde vervoersmogelijkheden reizen steeds meer mensen naar exotische bestemmingen. Ook het medisch toerisme is de laatste tijd sterk gestegen, onder andere voor cosmetische chirurgie en ingrepen die zorgverzekeraars in Nederland niet vergoeden.23 Reizen naar Zuidoost-Azië hebben een hoog risico op besmetting met een EPB: gemiddeld is 34% tijdens de reis met een EPB besmet geraakt, variërend van 75% met bestemming Zuidoost-Azië, tot 40-50% met bestemming Centraal-Oost Azië, het Midden-Oosten en Noord-Afrika.10 Risicofactoren voor EPB-besmetting tijdens de reis waren gebruik van antibiotica, reizigersdiarree en chronische darmziekten, maar de grootste risicofactor bleef de reisbestemming.112425 Opvallend was dat contact met zorginstellingen niet nodig was voor het verkrijgen van een EPB.10 De kans op overdracht/verspreiding van EPB tussen personen varieerde van 12 tot 22%.102526
Behalve van mens tot mens kan EPB zich ook via voeding en milieu verspreiden
Migranten
Door een toenemende vluchtelingenstroom en arbeidsmigratie in Nederland verandert ook de etnische achtergrond van de patiëntenpopulatie in de huisartsenpraktijk. De verwachting is dat de komende jaren meer vluchtelingen en (arbeids)immigranten zich in Nederland zullen vestigen en een beroep op de gezondheidszorggaan doen.2728 U zult naast culturele verschillen ook rekening moeten houden met variabelen als het hogere AB-gebruik en de hogere prevalentie van EPB in het land van herkomst, met name Afghanistan, Iran, Syrië, Somalië, Soedan en Eritrea, vergeleken met Nederland.89 Wereldwijd neemt de prevalentie van EPB toe, met grote verschillen per land en per regio.29 Verschillen in voorschrijfgedrag en antibioticagebruik zijn belangrijke factoren die van invloed zijn op het risico op dragerschap van EPB bij migranten.30 Naast EPB blijken zij ook vaker drager te zijn van een methicillineresistente Staphylococcus aureus.31
Conclusie
Concluderend kunnen we zeggen dat u alert moet zijn op het voorkomen van EPB in uw patiëntenpopulatie. Zeker wanneer u een praktijk hebt met veel migranten en veel reislustige patiënten moet u rekening houden met een mogelijke EPB-infectie als de gangbare therapie faalt. EPB is niet alleen een probleem van zorginstellingen, maar ook van de community en van u als huisarts. Bij overplaatsing tussen zorginstellingen moet u EPB-dragerschap of -infectie vermelden in de overdracht en (tijdelijk) in het EPD om transmissie van EPB tussen de eerste en tweede lijn, en tussen zorginstellingen onderling tot een minimum te beperken. Om het antibioticaresistentievraagstuk te beheersen is nauwe samenwerking tussen de instellingen en zorgverleners essentieel.
De kern
-
Het aantal infecties veroorzaakt door extended- spectrumbètalactamaseproducerende bacteriën (EPB) neemt wereldwijd toe, ook in de eerste lijn.
-
EPB zijn meestal ook resistent voor aminoglycosiden, cotrimoxazol en (fluoro)quinolonen.
-
Bij een EPB-infectie is behandeling met bètalactamantibiotica gecontra-indiceerd.
-
Bekende risicofactoren voor EPB-dragerschap of -infectie zijn veelvuldig antibioticagebruik, migratie, reizen en opname in zorginstellingen.
-
Regionale zorgnetwerken zullen de samenwerking tussen de eerste en tweede lijn verbeteren en zodoende bijdragen aan het beheersen van het extended-spectrumbètalactamaseprobleem.
-
Huisartsen moeten alert zijn op infectie met EPB als de standaardbehandeling faalt en risicofactoren aanwezig zijn. Goede overdracht tussen instellingen, inclusief EPB-dragerschap/-infectie, is van belang.
Literatuur
- 1.↲. https://amr-review.org/
- 2.↲↲↲↲↲NetmapMaran 2017, http://www.swab.nl/swab/cms3.nsf/uploads/5512AF93D2C71409C125814E003BA085/$FILE/Nethmap-Maran%202017.pdf
- 3.↲Padmini N, Ajilda AAK, Sivakumar N, Selvakumar G. Extended spectrum β-lactamase producing Escherichia coli and Klebsiella pneumoniae: critical tools for antibiotic resistance pattern. J Basic Microbiol 2017;57:460-70.
- 4.↲Oteo J, Perez-Vazquez M, Campos J. Extended-spectrum [beta]-lactamase producing Escherichia coli: changing epidemiology and clinical impact. Curr Opin Infect Dis 2010;23:320-6.
- 5.↲Paterson DL, Bonomo RA. Extended-spectrum beta-lactamases: a clinical update. Clin Microbiol Rev 2005;18:657-86.
- 6.↲ http://www.swab.nl/swab/cms3.nsf/viewdoc/20BCD3983B5C390AC12575850031D33D
- 7.↲RIVM. Veelgestelde vragen ESBL. . http://www.rivm.nl/Documenten_en_publicaties/Algemeen_Actueel/Veelgestelde_vragen/Infectieziekten/Veelgestelde_vragen_ESBL
- 8.↲↲Ahmed SS, Alp E, Ulu-Kilic A, Dinc G, Aktas Z, Ada B, et al. Spread of carbapenem-resistant international clones of Acinetobacter baumannii in Turkey and Azerbaijan: a collaborative study. Eur J Clin Microbiol Infect Dis 2016;35:1463-8.
- 9.↲↲Ahmed MO, Daw MA. Mapping the travel route of African refugees who traverse Libya to determine public health implications for Libya and the North-African region. Travel Med Infect Dis 2016;14:162-4.
- 10.↲↲↲↲Arcilla MS, Van Hattem JM, Haverkate MR, Bootsma MCJ, Van Genderen PJJ, Goorhuis A, et al. Import and spread of extended-spectrum β-lactamase-producing Enterobacteriaceae by international travellers (COMBAT study): a prospective, multicentre cohort study. Lancet Infect Dis 2017;17:78-85.
- 11.↲↲Huizinga P, Van den Bergh MK, Van Rijen M, Willemsen I, Van ’t Veer N, Kluytmans J, et al. Protonpump inhibitor use is associated with extended-spectrum β-lactamase-producing Enterobacteriaceae rectal carriage at hospital admission: a cross-sectional study. Clin Infect Dis 2017;64:361-3.
- 12.↲↲↲IGZ. Rapport instellingen in ouderenzorg hygiëne en infectiepreventie. . https://www.igj.nl/actueel/nieuws/2015/04/28/hygiene-infectiepreventie-verpleeghuizen-onvoldoende
- 13.↲. https://www.nhg.org/themas/publicaties/richtlijn-infectiepreventie-de-huisartsen-en-verloskundigenpraktijk
- 14.↲. http://www.publiekzipnet.nl/protocollen/hoe-te-handelen-bij-infecties/1279-esbl-informatiefolder
- 15.↲. http://www.publiekzipnet.nl/protocollen/esbl
- 16.↲. http://www.rivm.nl/Onderwerpen/W/Werkgroep_Infectie_Preventie_WIP
- 17.↲ECDC. Risk assessment on the spread of carbapenemase-producing Enterobacteriaceae (CPE), through patient transfer between healthcare facilities, with special emphasis on cross-border transfer. Stockholm: ECDC, 13 September 2011.
- 18.↲. https://www.nemokennislink.nl/publicaties/optimaliseren-van-het-antibioticagebruik/
- 19.↲Leverstein-van Hall MA, Dierikx CM, Cohen Stuart J, Voets GM, Van den Munckhof MP, Van Essen-Zandbergen A, et al. Dutch patients, retail chicken meat and poultry share the same ESBL genes, plasmids and strains. Clin Microbiol Infect 2011;17:873-80.
- 20.↲Huijbers PM, Blaak H, De Jong MC, Graat EA, Vandenbroucke-Grauls CM, De Roda Husman AM. Role of the environment in the transmission of antimicrobial resistance to humans: a review. Environ Sci Technol 2015;49:11993-2004.
- 21.↲Blaak H, De Kruijf P, Hamidjaja RA, Van Hoek AH, De Roda Husman AM, Schets FM. Prevalence and characteristics of ESBL-producing E. coli in Dutch recreational waters influenced by wastewater treatment plants. Vet Microbiol 2014;171:448-59.
- 22.↲Reuland EA, Al Naiemi N, Raadsen SA, Savelkoul PH, Kluytmans JA, Vandenbroucke-Grauls CM. Prevalence of ESBL-producing Enterobacteriaceae in raw vegetables. Eur J Clin Microbiol Infect Dis 2014;33:1843-6.
- 23.↲Lunt N, Carrera P. Medical tourism: assessing the evidence on treatment abroad. Maturitas 2010;66:27-32.
- 24.↲Reuland EA, Al Naiemi N, Kaiser AM, Heck M, Kluytmans JA, Savelkoul PH, et al. Prevalence and risk factors for carriage of ESBL-producing Enterobacteriaceae in Amsterdam. J Antimicrob Chemother 2016;71:1076-82.
- 25.↲↲Hassing RJ, Alsma J, Arcilla MS, Van Genderen PJ, Stricker BH, Verbon A. International travel and acquisition of multidrug-resistant Enterobacteriaceae: a systematic review. Euro Surveill 2015;20.
- 26.↲Paltansing S, Vlot JA, Kraakman ME, Mesman R, Bruijning ML, Bernards AT, et al. Extended-spectrum β-lactamase-producing enterobacteriaceae among travelers from the Netherlands. Emerg Infect Dis 2013;19:1206-13.
- 27.↲. https://www.cbs.nl/nl-nl/nieuws/2017/05/meer-personen-uit-oost-europa-aan-het-werk-in-nederland
- 28.↲. https://www.cbs.nl/nl-nl/nieuws/2017/05/migratie-zorgt-voor-relatief-hoge-bevolkingsgroei
- 29.↲Pitout JD, Laupland KB. Extended-spectrum beta-lactamase-producing Enterobacteriaceae: an emerging public-health concern. Lancet Infect Dis 2008;8:159-66.
- 30.↲Canton R, Novais A, Valverde A, Machado E, Peixe L, Baquero F, et al. Prevalence and spread of extended-spectrum beta-lactamase-producing Enterobacteriaceae in Europe. Clin Microbiol Infect 2008;14 Suppl 1:144-53.
- 31.↲Ravensbergen SJ, Berends M, Stienstra Y, Ott A. High prevalence of MRSA and ESBL among asylum seekers in the Netherlands. PLoSOne 2017;12:e0176481.
Reacties
Er zijn nog geen reacties.